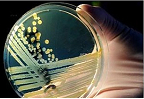
Тайна отравлений кишечной палочкой в Европе раскрыта Тайна отравлений кишечной палочкой в Европе раскрыта

|
  |
МЕДИЦИНСКИЙ ПОРТАЛ УЗБЕКИСТАНА |

В рамках проекта «Повышение качества медицинского обслуживания больных с инфекционными заболеваниями» областные инфекционные больницы и областные центры санитарно-эпидемиологического надзора Андижанской, Джизакской, Сырдарьинской и Ташкентской областей будут оснащены современным медицинским оборудованием, а также повышена квалификация их медицинского персонала.
13.06.2011
Стволовые клетки из пуповины вылечили ребенка от рака головного мозга
В возрасте 22 месяцев у маленькой Альбы Мартинес была обнаружена опухоль головного мозга, лечение такой патологии требует нескольких курсов химиотерапии, которая убивает не только раковые клетки, но и поражает собственную кроветворную систему пациента. Однако родители малышки предусмотрительно сохранили при ее рождении ее пуповину, желая обеспечить дочери своеобразное «страхование жизни», ведь в пуповине, как и в пуповинной крови, содержится высокая концентрация мезенхимальных стволовых клеток.

Речь идет о таблетке, которая прицельно влияет на проблемный ген, присутствующий в меланоме. Как показал эксперимент, средство позволяет сократить риск смерть почти на две трети у пациентов с развитой формой рака.

Британские исследователи испытали на мышах лекарственное средство, способное заставлять сердце залечивать повреждения, причиненные инфарктом.

Малыш постоянно кашляет. Аптечка уже переполнена лекарствами от кашля, перепробованы все народные средства, а толку нет. Малыша постоянно мучает надрывной кашель, который появляется регулярно. И снять эти приступы кашля очень сложно. Так в чем тут дело?

эффективнее всего лечить грипп антибиотиками.. Это грубейшее заблуждение! Антибиотики действуют только на бактерии. Грипп же вызывают не бактерии, а вирусы. Поэтому антибиотики на них совершенно не действуют — нужны только антивирусные препараты. Иное дело, когда к гриппу присоединяется еще и бактериальная инфекция, например пневмония. Тогда без антибиотиков никак не обойтись.

Волонтёры американской некоммерческой организации Medical Teams International (Международная лига врачей) содействуют в развитие неотложной медицинской помощи в Узбекистане. Об этом заявил журналистам специалист по неотложной медицинской помощи, нефролог и менеджер по проектам «MTI» в Узбекистане Комилжон Хамзаев, передает корреспондент ИА REGNUM.

Генеральный секретарь ООН Пан Ги Мун сообщил, что "в борьбе со СПИДом мировое сообщество достигло значимых успехов".

Представьте себе крохотного "жучка" жадно глотающего еспрессо на протяжении всего дня. Недавно обнаруженная бактерия живет именно в этом веществе, используя специализированные пищеварительные энзимы, чтобы расщеплять кофеин на питательные вещества, обеспечивающие ей непрерывный рост и развитие. "Мы выделили новую расщепляющую кофеин бактерию, под названием Pseudomonas putida CBB5П, действия которой способствуют тому, что кофеин распадается на такие вещества, обеспечивающие ей непрерывный рост и развитие.
Вспышка инфекции кишечной палочки E. coli, которая распространилась в 12 странах и стала причиной смерти 19 человек, может быть связана с фестивалем Гамбурга, прошедшего в мае, об этом стало известно от официальных властей в субботу.Немецкий еженедельный выпуск газеты "Focus" сообщил, что авторитетные специалисты рассмотрели подробно фестиваль порта в Гамбурге ,проходивший 6-8 мая, в котором приняли участие 1,5 миллионов посетителей из Германии и других стран

В поисках способов сохранения крепкой мышечной массы, которая слабеет в связи с болезнями и старением, исследователи обнаружили естественный состав, который сможет решить эту проблему. В сведениях, опубликованных в июньском выпуске издания "Cell Metabolism", ученые идентифицировали компонент яблочной кожуры как перспективного нового кандидата среди медикаментов для лечения широко распространенного ослабляющего состояния мышц, которое настигает всех рано или поздно.

Недавно экспертами было установлено, что дети, живущие около атомной электростанции в Великобритании не подвержены большему риску развития у них лейкемии, чем дети, живущие где-нибудь в других областях страны.
24.05.2011
Исследователи создали регенерирующий нанопластырь для сердца
Когда человек переносит инфаркт, часть его сердца умирает. Нервные клетки на сердечной стенке и специальный класс клеток, которые спонтанно расширяются и сокращаются, обеспечивая отличную синхронность в сердцебиении, погибают навсегда.

Исследование Университета Аделаиды показало, что томаты могут быть эффективной альтернативой медикаментам, способствующих уменьшению холестерола и кровяного давления, предотвращая, таким образом, сердечнососудистые заболевания.
12.05.2011
Мифы о первой помощи
Неважно, откуда и когда они взялись, но практически каждый наш человек имеет некие знания об оказании первой помощи. Увы, в большинстве случаев этот набор знаний представляет собой кашу из стереотипов и слухов, и применение этой каши на практике не просто бесполезно, но и опасно.
12.05.2011
Никотин и кокаин одинаково влияют на мозг
Новое исследование в области неврологии показало, что эффекты никотина на регионы мозга, участвующие в формировании вредных привычек те же, что и у кокаина.
30.04.2011
Обнаружены гены, управляющие старением стероида
Восемь генов, которые управляют уровнями основного стероида (вещество животного или растительного происхождения, обладающее высокой биологической активностью), производимого надпочечной железой, как выяснилось, играют важную роль в процессе старения и долголетии человека.
30.04.2011
Ученые установили 3 типа кишечной микрофлоры человека
В будущем, когда пациента будут готовить к хирургической операции, врачи осведомятся не только о наличии аллергии на те, или иные препараты и о группе крови, но также о типе кишечника пациента. Ученые Европейской Молекулярной Биологической Лаборатории (EMBL) в Хейделберге, Германии, и сотрудники международного консорциума MetaHIT, обнаружили, что люди обладают 3 различными типами кишечника.
30.04.2011
4 упражнения, помогающие людям с диагнозом рака
Иногда физические упражнения могут быть достаточно сложными для здоровых людей, не говоря уже о людях, которые ведут отчаянную борьбу с раковыми заболеваниями.
30.04.2011
Новый метод лечения болезненного лишая у взрослых
Исследователи из Университета Джорджии и Йельского Университета обнаружили состав с потенциалом более эффективным, чем уже существующие вещества, используемые для лечения болезненных волдырей, известных как лишай
|
Copyright © WWW.MED.UZ - Медицинский портал Узбекистана, 2005-2011 Все права защищены. Вся информация, размещённая на данном веб-сайте, предназначена только для персонального использования и не подлежит дальнейшему воспроизведению и/или распространению в какой-либо форме, иначе как с письменного разрешения компании MedNetSoft |